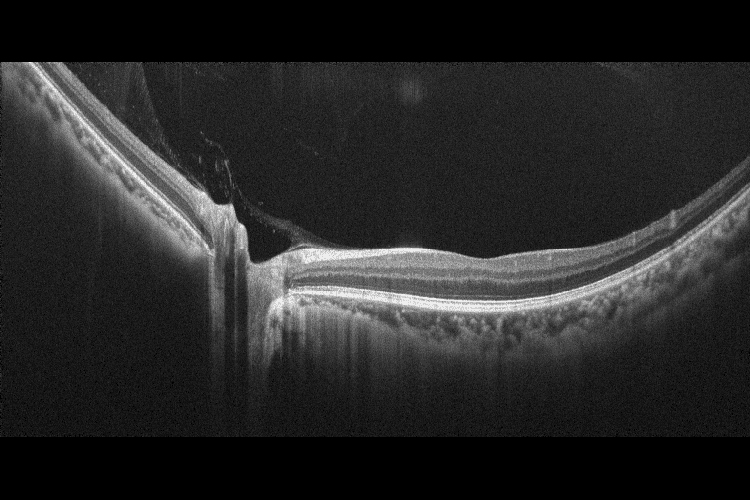
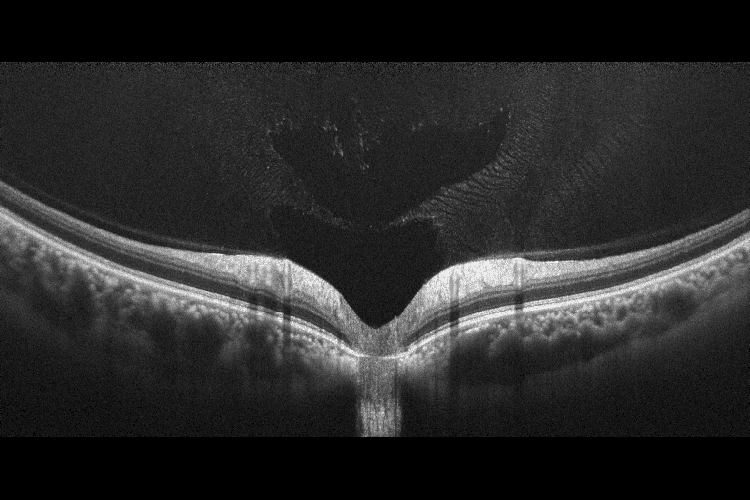

АКЦІЇ! ПЕРЕГЛЯНУТИ ПОВНИЙ ПЕРЕЛІК ДОСТУПНИХ ПРОПОЗИЦІЙ МОЖНА ТУТ
Оптико-когерентний томограф XEPHILIO OCT-R1

Під замовлення
Стан: новий
Виробник: Canon Inc. (Японія)
Гарантія: 12 місяців
Сервісний супровід: гарантійний та післягарантійний
Умови оплати
- безготівковий розрахунок
Доставка
- згідно умов договору постачання
Повністю автоматизована робота
OCT-R1 — це повністю автоматизований пристрій, який поєднує в собі технології спектральної ОКТ та фундус-камери, щоб забезпечити швидке, точне та комплексне обстеження очей.
Він оснащений функцією зовнішнього автоматичного вирівнювання і відстеження, а також автоматичним відстеженням, фокусуванням і захопленням зображення сітківки. Крім того, він пропонує повністю автоматизовані послідовні протоколи обстеження та аудіо супровід, що запускаються за один дотик.
OCT-R1 є чудовим вибором для професіоналів з догляду за очима, які цінують високу якість зображення, швидкість, точність і ергономічність

Сучасний пристрій 2-в-1, що поєднує найкраще з обох інструментів
Оптична когерентна томографія (ОКТ) високої роздільної здатності та фотографія сітківки високої чіткості об’єднані в доступному ОКТ-пристрої початкового рівня з невеликою площею та гнучким розташуванням, що пропонує перевагу легкого розміщення в будь-якій кімнаті та навіть розміщення в кут, що дозволяє оптимально використовувати доступний простір за допомогою сенсорного екрану.
Сканування з високою роздільною здатністю
Поєднання ОКТ і ретинальної камери високої чіткості в OCT-R1 робить його ідеальним рішенням для скринінгу та практик із високою пропускною здатністю пацієнтів. Він пропонує широкий спектр високоякісних зображень сканування розміром до 14,7 x 13,4 мм з роздільною здатністю 32,5 МП і спеціальними алгоритмами, які створюють зображення високої чіткості та неперевершеного кольору.
Інтуїтивно зрозуміле та універсальне програмне забезпечення
Комплексне програмне забезпечення RX розроблено для автоматичного об’єднання інформації як з ОКТ, так і з ретинальної камери для повного звітування та діагностичної підтримки. Воно оптимізоване для роботи з сенсорним екраном із великими та чіткими піктограмами, які спрощують навігацію.
Це дозволяє легко порівнювати зображення, отримані при різних обстеженнях, уможливлюючи моніторинг прогресування та подальше спостереження за зображеннями, отриманими під час різних візитів.

Послідовні протоколи з аудіоінструкціями
Xephilio OCT-R1 пропонує повністю автоматизований послідовний протокол обстеження, який можна ініціювати лише одним дотиком. Аудіоінструкції допомагають пацієнту протягом усього процесу дослідження оптичної когерентної томографії, починаючи від початкового вирівнювання до отримання ОКТ-сканування. Ця вдосконалена функція підтримує кілька мов і оптимізує процес візуалізації, забезпечуючи точність і узгодженість даних візуалізації, отриманих на обох очах.

Функція автоматичного сповіщення про якість зображення
Результати послідовних обстежень візуалізуються в комплексному звіті з функцією автоматичного сповіщення про якість зображення, яка сповіщає експерта, коли зроблене зображення має недостатню якість. Послідовність протоколу обстеження може бути налаштована відповідно до вимог користувачів і може включати до 4 обстежень ОКТ + 1 фото очного дна або 5 обстежень ОКТ для обох очей.

Швидкі та послідовні дослідження
Xephilio OCT-R1 — це пристрій із широкими можливостями налаштування, який пропонує програмовані попередні налаштування обстеження, що дозволяє операторам комбінувати кілька режимів сканування в одному обстеженні. Ця унікальна функція зменшує дискомфорт пацієнта та покращує ефективність роботи в клініці. Режим широкого 3D-сканування (13x10 мм), який поєднує сканування Glaucoma 3D і Disc 3D в одне сканування, значно скорочує процес обстеження глаукоми з точним спостереженням за прогресуванням.

Сканування з високою роздільною здатністю
Xephilio OCT-R1 включає функцію усереднення, яка дозволяє комбінувати до 50 множинних сканувань для усунення будь-якого оптичного шуму за допомогою автоматичної сегментації з підтримкою ШІ. Він здатний робити дуже великі ділянки сканування 14,7 мм × 13,4 мм із дуже високою роздільною здатністю 1536 A-сканів у ширину.

Вбудована цифрова ретинальна камера EOS 32,5 МП
Вбудована в OCT-R1, ретинальна камера тепер є частиною оптичної системи, яка ще більше покращує якість отриманих зображень сітківки. Удосконалена технологія Canon EOS Retina, інтегрована в OCT-R1, покращує діагностичні можливості та результати для пацієнтів завдяки функції повного автофокусування та зйомки при оптимізованому спостереженні за світлом та інтенсивністю спалаху.
Технологія Canon Opacity Suppression
Цей унікальний і складний програмний інструмент відновлює початкову яскравість і колір сітківки. Технологія зменшує несприятливий вплив помутнінь очей, таких як катаракта, для більш чіткого перегляду кровоносних судин, що призводить до того, що незрозумілі структури стають більш впізнаваними.


Цифрові фільтри
Цифрові фільтри REDFREE і COBALT забезпечують чудову якість зображення, порівнянну з оптичними фільтрами, завдяки процесору зображень DIGIC, який використовує спеціальні алгоритми для забезпечення оптимальних параметрів зображення реальних кольорів для зображення сітківки.


Широкоформатне зображення
Комбінуйте до 20 зображень, щоб охопити область до 100 градусів, допомагаючи оператору з автоматичними вказівками фіксації.

ОКТ Ангіографія з ANGIO Expert
Це додаткове програмне забезпечення використовує складні алгоритми для отримання інформації про рух із томограм, отриманих OCT-R1. Воно дозволяє візуалізувати навіть найдрібніші кровоносні судини як у 2D, так і в 3D форматах. Поєднання Xephilio OCT-R1 із програмним забезпеченням ANGIO Expert надає фахівцям потужний інструмент для візуалізації та аналізу мікроциркуляторного русла сітківки з винятковою деталізацією та точністю. ANGIO Expert також має технологію Intelligent Denoise, технологію штучного інтелекту, яка покращує зображення оптичної когерентної томографії ангіографії (ОКТА), зменшуючи шум зображення, покращуючи деталі та покращуючи видимість за лічені секунди, а також здатність створювати панорамні зображення, поєднуючи 4–5 сканувань ОКТА, що допомагає візуалізувати патології сітківки на дальній периферії.
Функція інтелектуального усунення шумів Canon на основі штучного інтелекту пропонує нову якість зображень ОКТА на основі лише одного сканування – без необхідності отримувати та об’єднувати кілька зображень. Технологія Canon Deep Learning — це революційна технологія, яка базується на величезних обсягах клінічних даних для отримання зображень із значно зменшеним шумом зображення, підвищеною деталізацією та покращеною видимістю всього за кілька секунд.



| Загальні параметри | |
| Тип ОКТ | Спектральний ОКТ |
| Джерело світла | SLED |
| Центральна довжина хвилі | 880 нм |
| Роздільна здатність | 7 мкм |
| Швидкість сканування | 50 000 А-сканів/сек |
Ширина скана | 3 ~ 14,7 мм |
| Глибина скана | 2.3 мм |
| Мінімальний діаметр зіниці | 2.5 мм |
| Робоча відстань | 35 мм |
| Метод зображення фундуса | Ретинальна камера (зображення IR) |
Фотографія | Кольорова, Безчервона, Кобальт, Переднього сегменту та мозаїчні зображення |
| Кут фотографії | 45°/30° цифровий |
| Роздільна здатність | 32.5 Мпікселів / 63 лінії на мм |
| Мінімальний діаметр зіниці для ретинальної камери | 4 мм / 3,3 мм в режимі «small pupil» |
| Підборідник | Моторизований |
| Розміри (Ш х Г х В) | 335 х 490 х 473 мм |
| Вага | 23 кг |
| Параметри сканування ОКТ | |
Macula 3D | 1024 A-сканів х 128 B-сканів (горизонтальний) площа сканування 10 мм х10 мм |
Glaucoma 3D | 1024 A-сканів х 128 B-сканів (вертикальний) площа сканування 10 мм х10 мм |
Disk 3D | 512 А-сканів х 256 В-сканів (горизонтальний) площа сканування 6 мм х 6 мм |
Wide 3D | 512 A-сканів х 128 B-сканів; 1024 A-сканів x 1 13 x 10 мм, 13 мм |
Custom 3D | 1024 A-сканів х 128 B-сканів (горизонтальний/вертикальний) площа сканування 3 х 3 мм ~ 14.7 х 13.4 мм |
Multi Cross | 1024 A-сканів х 1 х 2 площа сканування 3 х 3 мм ~ 14.7 х 13.4 мм 1536 A-сканів х 1 х 2 площа сканування 6 х 6 мм ~ 14.7 х 13.4 мм Усереднення: 1/5/10/20 |
Cross | 1024 A-сканів х 1 х 2 площа сканування 3 х 3 мм ~ 14.7 х 13.4 мм 1536 A-сканів х 1 х 2 площа сканування 6 х 6 мм ~ 14.7 х 13.4 мм Усереднення: 1/5/10/20/50 |
| Radial | 1024 A-сканів х 12 площа сканування 3 х 3 мм ~ 14.7 х 13.4 мм 1536 A-сканів х 12 площа сканування 6 х 6 мм ~ 14.7 х 13.4 мм Усереднення: 1/5/10/20 |
| OCTA | ОКТ ангіографія (опція) |
| Режими сканування переднього відрізка | |
| Anterior 3D | 512 А-сканів х 256 В-сканів площа сканування 6 мм х 6 мм |
| Anterior Cross | 1024 A-сканів х 2 площа сканування 3 х 3 мм ~ 6 х 6 мм Вимірювання кута, відстані, AOD, TISA Усереднення 1 ~50 |
| Anterior Cross (Wide) | 1536 A-сканів х 2 16 мм Усереднення 1 ~50 |
| Anterior Radial (6 mm) | 1024 A-сканів х 12 діаметр сканування 6 мм Вимірювання товщини рогівки, товщини епітелія, відображення товщин рогівки в табличному вигляді Порівняння та прогрес товщин рогівки |
| Anterior Radial (9 mm) | 1536 A-сканів х 12 діаметр сканування 9 мм Вимірювання товщини рогівки, товщини епітелія, відображення товщин рогівки в табличному вигляді Порівняння та прогрес товщин рогівки |
Передній відрізок візуалізується без додаткової лінзи-адаптера


